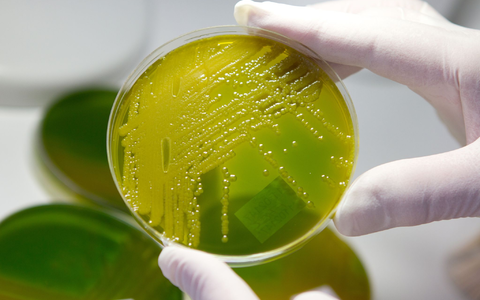
In Zwiebelmettwurst wurden die Bakterien nachgewiesen. (Archivbild) - Foto: Matthias Bein/dpa-Zentralbild/dpa In Zwiebelmettwurst wurden die Bakterien nachgewiesen. (Archivbild) - Foto: Matthias Bein/dpa-Zentralbild/dpa

Der Arzneimittelhersteller Viatris hat eine Charge des Retard-Medikaments ...
Adani Defence & Aerospace übergibt erste Charge inländischer ...
Der Pharmakonzern Zentiva zieht vorsorglich eine Charge ...
In einer Charge der ja! Frühlingsrollen mit feinem Gemüse ...
Eine bundesweite Warnung betrifft Rosinen der Firma Talia. ...
Du nimmst dir jeden Sonntag vor „ab morgen wird alles ...
Du glaubst du bewegst dich „eigentlich genug“ und schläfst ...
Du nimmst dir seit Monaten vor mehr Schritte zu gehen besser ...
Zwiebelmettwurst wegen Ehec-Gefahr zurückgerufen. In einer ...